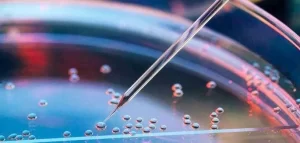

Laserowe usuwanie rumienia
Rumień na twarzy, szyi i dekolcie to problem, z którym boryka się bardzo wiele osób – zarówno kobiet, jak i mężczyzn. To problem nie tylko natury estetycznej – często powoduje spadek pewności siebie i nie pozwala w pełni cieszyć się